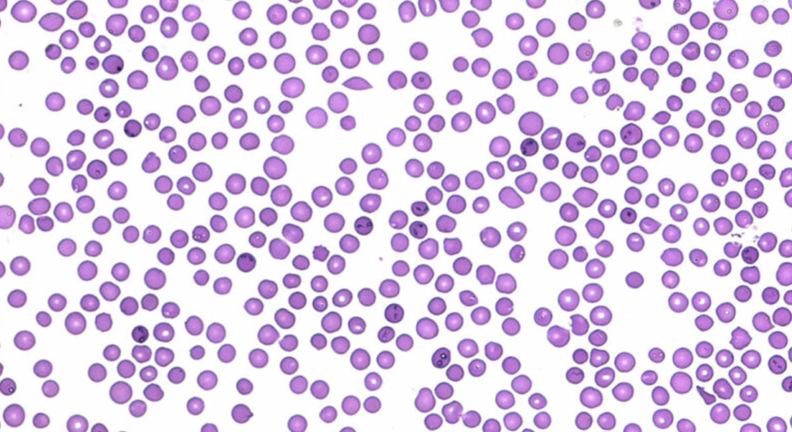
Bovine red blood cells infected with Babesia bovis.

2020
Circling in on a vaccine target for Babesia bovis
Babesia bovis is a tick-borne disease that annually kills millions of cattle worldwide.
Cannabis use blunts stress reactivity in female rats
Female rats developed a blunted physiological response to stress.
Meet the Class of 2021: Sarah Calvin
If you’re looking for four-leafed clovers, don’t forget to bring Sarah Calvin.
‘I can’t lose him, not yet’
Mocha stopped eating. Then, his owner realized he couldn’t see his food.
WSU veterinarians make list of top five pet gifts
Ideas to improve your pet’s health this holiday season.
Cinco no more
Moscow-Pullman Daily News
Sahlin Faculty Excellence Award
Dr. Erika Offerdahl is recognized for leadership in undergraduate science teaching and assessment for 2019-2020.